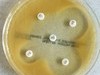

▲成大醫院薛亘佑醫師指出,20至40歲的年輕人,有發炎性背痛,又有僵直性脊椎炎的家族史,應考慮到醫院檢查是否為僵直性脊椎炎,並及早治療。(圖/成醫提供)
記者林悅/台南報導
一名黃姓大三學生本身是籃球系隊,2年前開始每周好幾天清晨起床後覺得下背疼痛,甚至清晨2、3點因劇烈下背痛而痛醒,患者有持續規律運動,但背痛和運動傷害似乎關係不大,曾懷疑是否床鋪太硬,即使換過高級床墊,改善仍有限,成大醫院風濕免疫科薛亘佑醫師指出,其實他是很典型的僵直性脊椎炎。
薛亘佑醫師說,這種起床後的疼痛常常造成黃同學無法下床,雖會慢慢緩解,但是也曾好幾次因而來不及去上課;在做一些「緩和的柔軟體操」後大約半小時,輕度的症狀就有明顯改善。
薛亘佑醫師說,其實黃同學是很典型的僵直性脊椎炎,除了症狀符合之外,他的父親也是僵直性脊椎炎的患者,而遺傳基因「人類血球抗原HLA.B27」扮演著重要角色。
近幾年來僵直性脊椎炎的治療,主要在適量、規則地服用消炎止痛藥(NSAIDs),適度的復健運動,並搭配免疫調節藥物以及生物製劑的發明使用;病患的症狀也在規則服用藥物後得到明顯改善。
薛亘佑醫師表示,僵直性脊椎炎會影響脊椎的活動度而造成僵硬的症狀,疾病初期的僵硬常是發炎造成疼痛而影響活動,可能在發炎改善後即可恢復;然而對於經歷疾病數年到數十年的「疾病中後期」病人,X光影像上甚至已看到被稱為「竹竿病」的類似竹子般沾粘,此時不可逆的變形會讓僵硬和活動度不易改善。
至於要確認僵直性脊椎炎,除了抽血、影像學X光檢查外,更要看其是否有「發炎性背痛」的特異性症狀,如:「休息加重、運動改善、影響夜間睡眠、晨間僵硬超過30分鐘」等,與單純肌肉韌帶疼痛「活動會惡化、休息可以改善」完全相反。而估計有9成的下背痛是單純肌肉韌帶疼痛,或醫學上稱為「機械性背痛」。
薛亘佑醫師指出,40歲前、尤其20至40歲的年輕人,有發炎性背痛,又有僵直性脊椎炎的家族史,應考慮到醫院檢查是否為僵直性脊椎炎,並及早治療。

讀者迴響